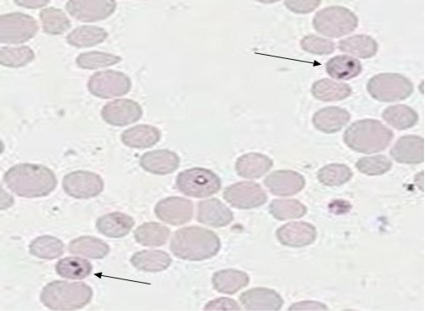

Journal of Infection and Molecular Biology
Research Article
J. Inf. Mol. Biol. 5(1): 1-6
Figure 1
Giemsa stained microplate showing characteristics of babesia bovis infection. Thin arrow shows Babesia sp. inside the bovine erythrocytes
Figure 2
Representative gel showing the specificity of PCR for the efficient detection of B. bovisLane 1 & Lane 3: Negative samples, Lane 2 & Lane 4: positive sample for B. bovisat 491bp and Lane M, 1000bp DNA ladder marker